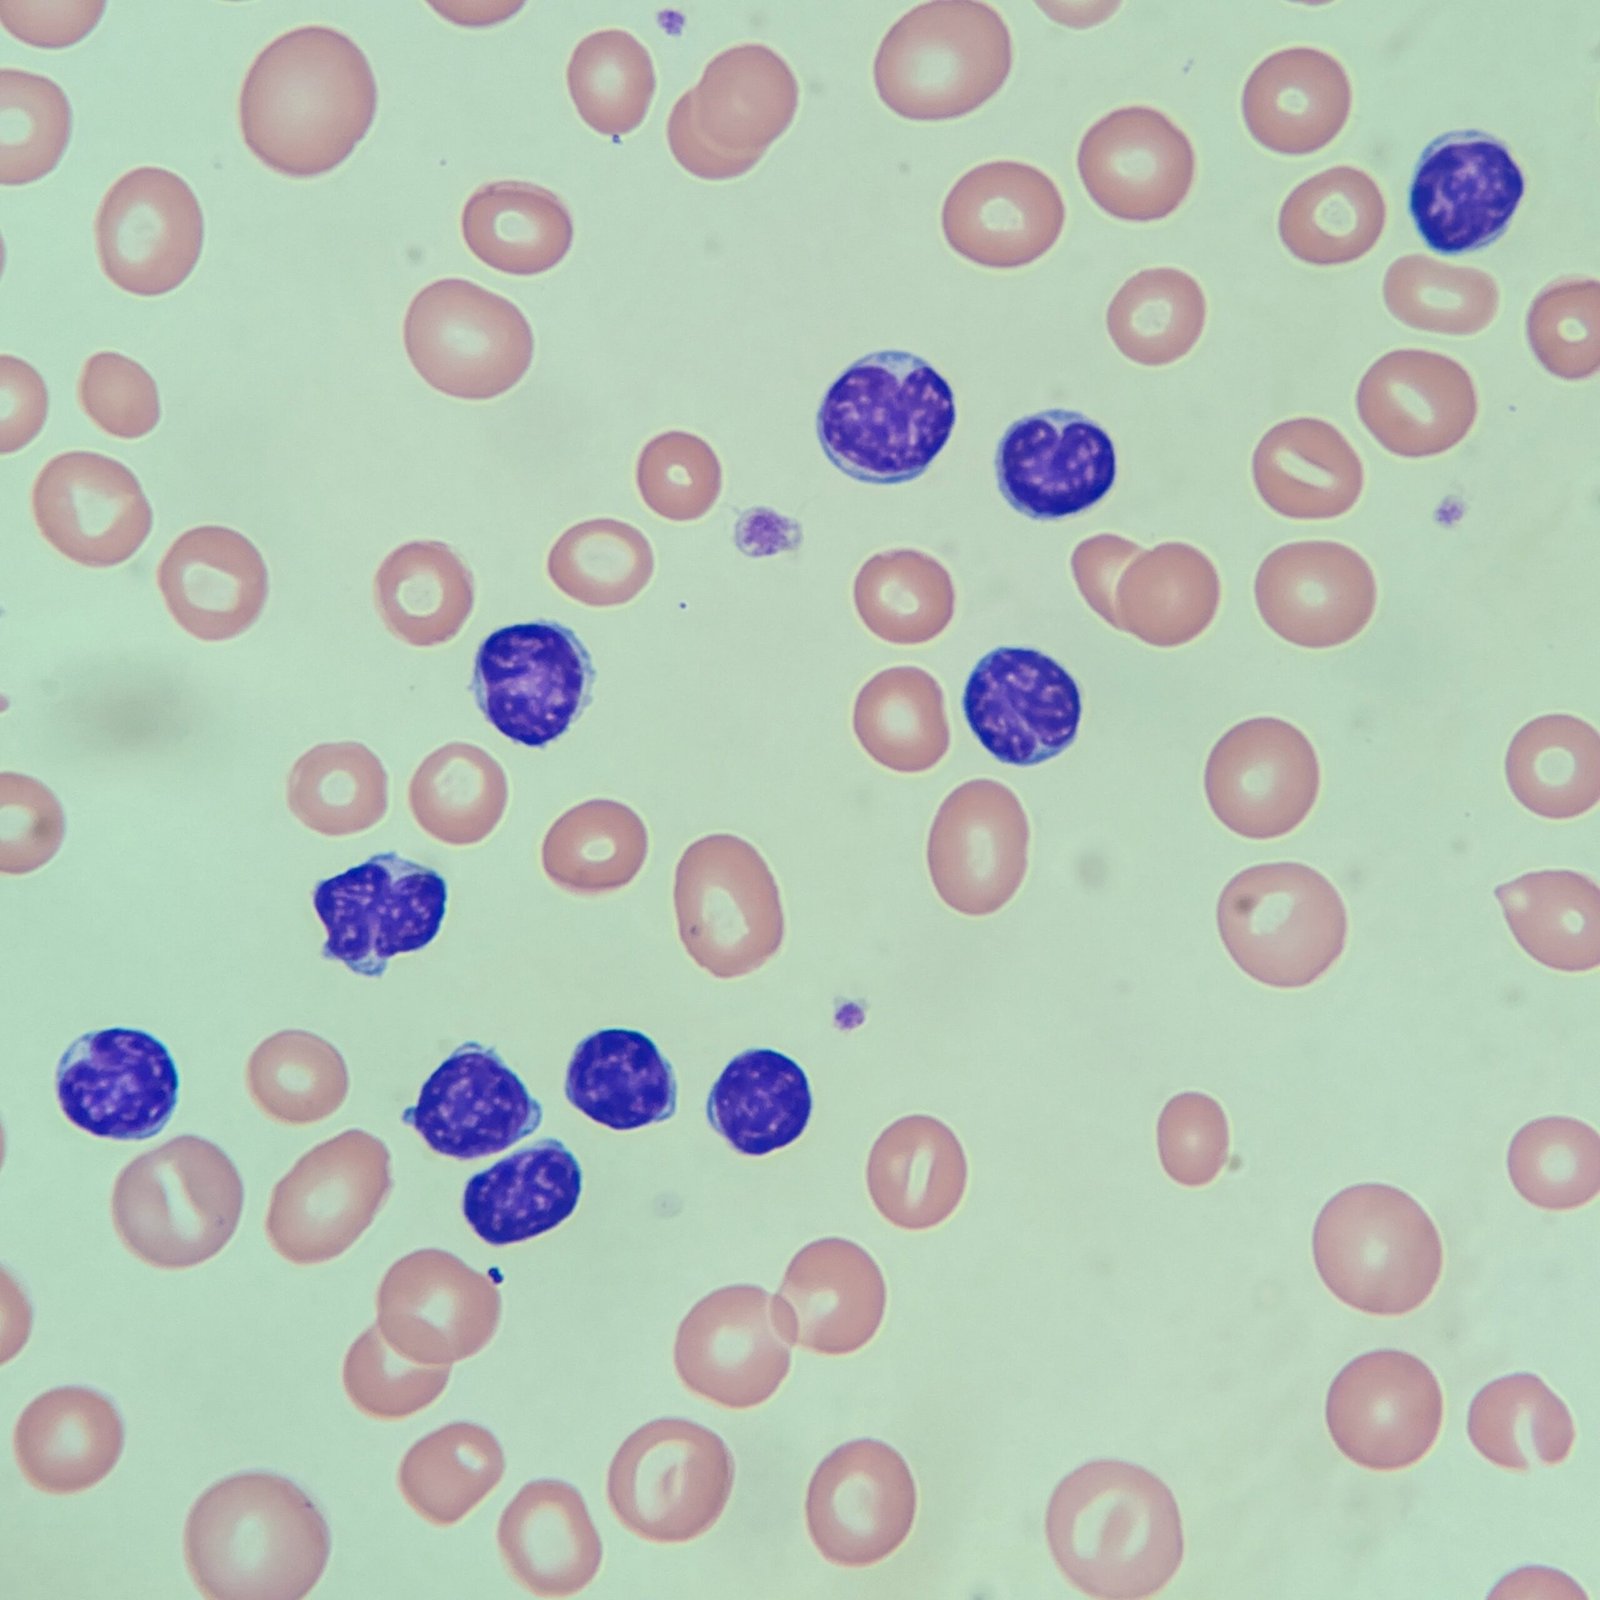
Cleaved Lymphocyte, White Blood Cell

Neutrophil Maturation
- Cytoplasm: As the neutrophil matures, the cytoplasm becomes less basophilic and more pink in color. The nuclear-to-cytoplasmic ratio also decreases as the nucleus takes up less space.
- Granules: Primary azurophilic granules are present in the early stages of neutrophil maturation and are replaced by the secondary specific granules. The primary granules are larger and stain much darker than the small, pinkish secondary granules which litter mature neutrophils.
- Nucleus: Nucleoli are typically only present in the earliest stages of neutrophil maturation. As the neutrophil matures, the looser chromatin condenses to form clumps. The nucleus also undergoes a segmentation process which is the most distinctive change in the neutrophil’s maturation.
Promyelocyte
Cytoplasm is basophilic with perinuclear hof. Azurophilic (primary) granules can be seen. Nucleus is usually round to oval-shaped with nucleoli and relatively fine chromatin.

Myelocyte
Cytoplasm is more pinkish blue with both primary and secondary granules. Nucleus usually eccentrically placed and may appear flattened on one side. Nucleoli usually not visible and chromatin is still fine with some clumping.

Metamyelocyte
Cytoplasm is pink with specific granules distributed throughout. Nucleus is indented less than half of the nucleus, forming a kidney-shape. Chromatin is clumped.

Band
Cytoplasm is pink with specific granules. Nucleus lacks segmentation and has uniform thickness, usually forming a “C” or “S” shape. Chromatin looser than that of segmented neutrophils.

Segmented
Cytoplasm is pink with specific granules. Nucleus is heavily clumped with thin filament connecting usually 2-5 lobes. Chromatin is heavily clumped.

Other White Blood Cells
Related Posts
-> Related: Neutrophil Inclusions & Abnormalities